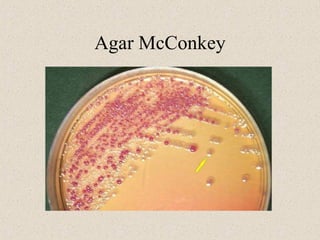
Agar McConkey
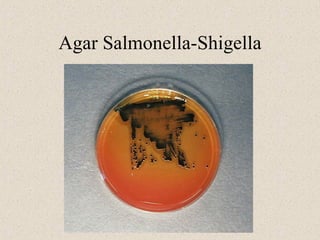
Agar Salmonella-Shigella
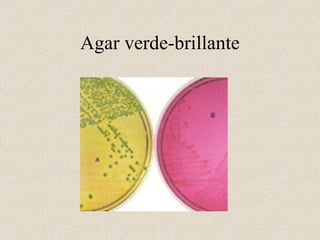
Agar verde-brillante
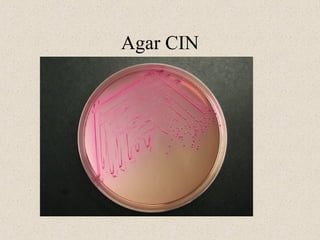
Agar CIN
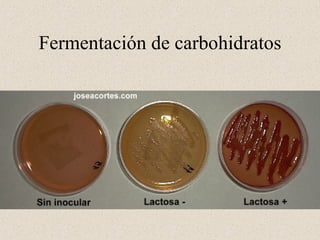
Fermentación de carbohidratos

Incrustar presentación






















Este documento lista diferentes tipos de medios de cultivo y pruebas de laboratorio utilizados para identificar bacterias, incluyendo agar McConkey, agar Hektoen, agar Salmonella-Shigella, agar XLD, agar verde-brillante y agar Wilson-Blair, así como pruebas como la prueba de la urea, la prueba de la FAD, la prueba de VoguesProskauer, la prueba del Indol y la prueba de la movilidad, entre otras, que pueden usarse para identificar géneros bacterianos como Salmon